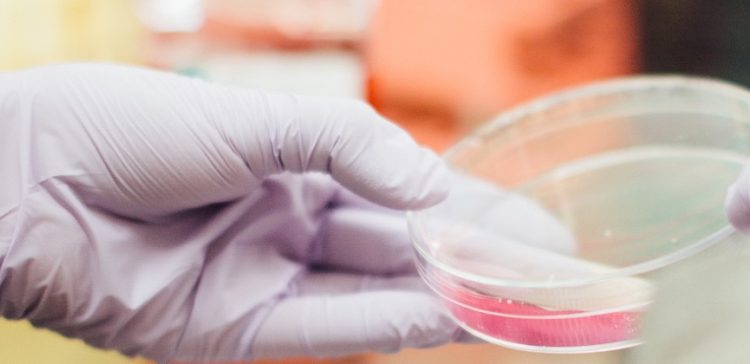
Ελληνίδα επικεφαλής σε σημαντική μελέτη που αποκαλύπτει νέα διάγνωση για τη νόσο Αλτσχάιμερ

Επιστήμονες στη Βρετανία, με επικεφαλής μια Ελληνίδα ερευνήτρια, ανέπτυξαν ένα πειραματικό μη επεμβατικό τεστ αίματος για την έγκαιρη διάγνωση της νόσου Αλτσχάιμερ. Στη μεγαλύτερη και πιο εμπεριστατωμένη μελέτη του είδους της, οι ερευνητές έχουν αναλύσει δείγματα αίματος για να δημιουργήσουν ένα νέο και μη επεμβατικό τρόπο για να βοηθήσουν στη διάγνωση της νόσου του Αλτσχάιμερ και στη διάκριση μεταξύ διαφορετικών τύπων νευροεκφυλιστικών διαταραχών.
Το τεστ φασματοχημικής ανάλυσης χρησιμοποιεί τεχνικές υπέρυθρης φασματοσκοπίας και χημειομετρίας για να αναλύσει δείγματα από πλάσμα αίματος, ανιχνεύοντας έτσι πρόωρες ενδείξεις της νευροεκφύλισης. Οι ερευνητές, με επικεφαλής τη Μαρία Παρασκευαΐδη της Σχολής Φαρμακευτικών και Βιοϊατρικών Επιστημών του Πανεπιστημίου του Κεντρικού Λανκασάιρ και τον καθηγητή Francis Martin, έκαναν τη σχετική δημοσίευση στο περιοδικό της Εθνικής Ακαδημίας Επιστημών των ΗΠΑ (PNAS).
Δοκίμασαν το τεστ σε δείγματα αίματος από 347 ανθρώπους με νευροεκφυλιστικές παθήσεις (Αλτσχάιμερ και άλλες), καθώς και σε 202 υγιή άτομα, ηλικίας 23 έως 90 ετών. Διαπιστώθηκε ότι το τεστ έχει ευαισθησία (sensitivity) και ειδικότητα (specificity) έως 86% στην ανίχνευση των περιπτώσεων Αλτσχάιμερ. Η ευαισθησία αφορά την ικανότητα του τεστ να ανιχνεύει τους αληθώς θετικούς σε μια ασθένεια, ενώ η ειδικότητα την ικανότητα του τεστ να ανιχνεύει τους αληθώς αρνητικούς, δηλαδή τους υγιείς.
Ειδικότερα για την πρόωρη ανίχνευση των περιστατικών Αλτσχάιμερ, το τεστ εμφανίζει ευαισθησία της τάξης του 80% και ειδικότητα 74%. Επιπλέον, το τεστ μπορεί να διακρίνει (διαφορική διάγνωση) τη νόσο Αλτσχάιμερ από την παρεμφερή άνοια που προκαλείται από τα σωμάτια Lewy, εμφανίζοντας ευαισθησία και ειδικότητα γύρω στο 90%.
Έως σήμερα δεν είναι εφικτή η έγκαιρη και ακριβής διάγνωση των νευροεκφυλιστικών παθήσεων. Τα υπάρχοντα τεστ είναι επεμβατικά, ακριβά και χρονοβόρα. Γι’ αυτό, αναζητούνται νέα αξιόπιστα τεστ έγκαιρης, γρήγορης, μη επεμβατικής και φθηνής διάγνωσης. Το υπό ανάπτυξη τεστ αφήνει υποσχέσεις ότι μελλοντικά θα μπορούσε όχι μόνο να επιβεβαιώσει πρόωρα την παρουσία της νευροεκφυλιστικής νόσου, αλλά και να διακρίνει ανάμεσα σε διαφορετικές μορφές άνοιας.
Η Μ. Παρασκευαΐδη αποφοίτησε από το Τμήμα Χημείας του Πανεπιστημίου Ιωαννίνων και πραγματοποιεί διδακτορική έρευνα στο Πανεπιστήμιο του Κεντρικού Λανκασάιρ.
www.ellines.com